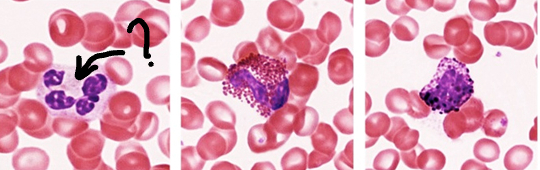
<p>Identify the leukocyte:</p>
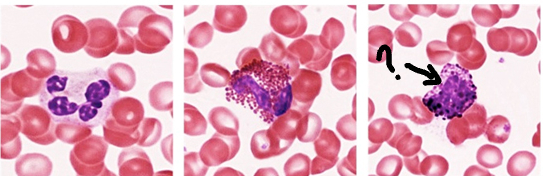
<p>Identify the leukocyte:</p>
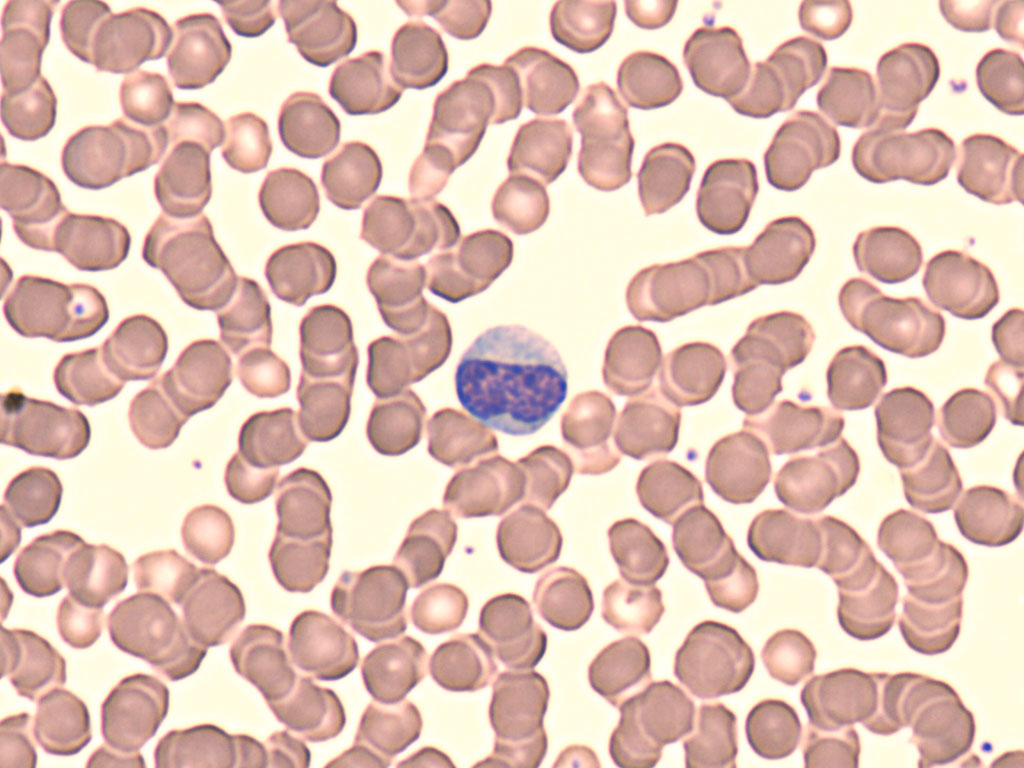
<p>Identify the leukocyte:</p>
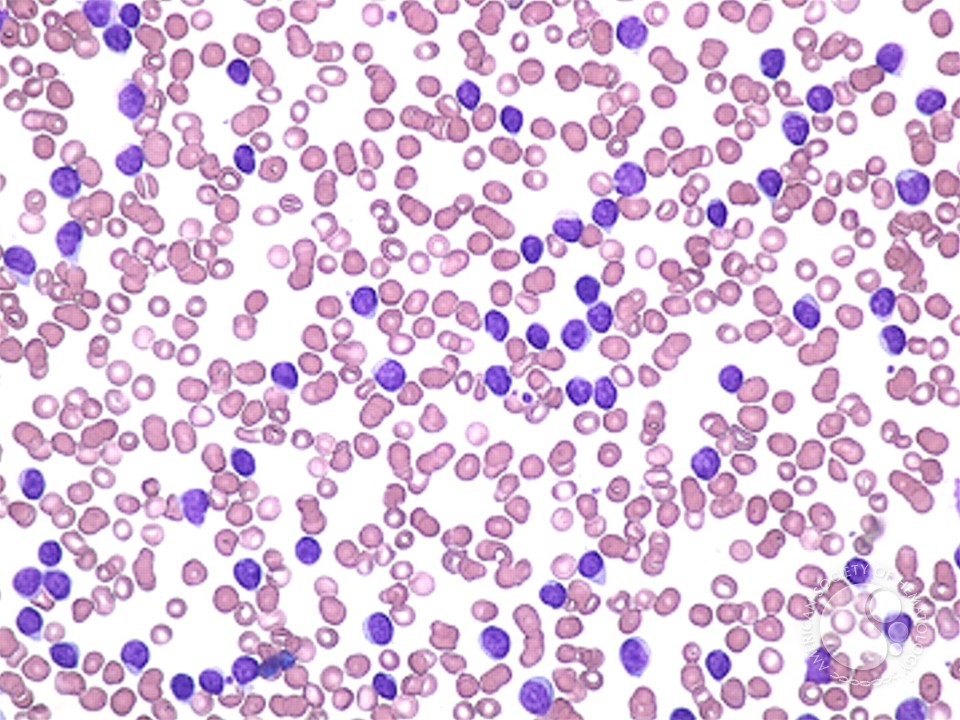
<p>This smear shows abnormally elevated lymphocytes:</p>

1/76
Looks like no tags are added yet.
Name | Mastery | Learn | Test | Matching | Spaced | Call with Kai |
|---|
No analytics yet
Send a link to your students to track their progress
Match each glial cell with its primary function:
Astrocyte
Structural support + blood-brain barrier
Match each glial cell with its primary function:
Oligodendrocyte
Forms myelin in CNS
Match each glial cell with its primary function:
Microglia
Immune defense/phagocytosis
Match each glial cell with its primary function:
Ependymal cell
Produces and circulates CSF
Match each glial cell with its primary function:
Schwann cell
Forms myelin in PNS

Identify the labeled neuron structure.
Axon hillock
Astrocytes are primarily found in the ______ and help maintain the ______.
Word Bank: CNS, PNS, ventricles, gray matter, white matter
CNS; blood-brain barrier (closest option: gray matter environment)
Which glial cell is found in the PNS and is responsible for myelination?
Schwann cell

Identify the structure in this axon cross-section:
Myelin sheath
What is the function of the Myelin Sheath identified in Question 5?
Increases conduction velocity

Identify the CNS tissue shown:
Cerebellum
What is the major neuron present in the Cerebellum tissue from Question 7?
Purkinje cell

Identify this tissue:
Cerebrum
What is the major neuron present in the Cerebrum tissue from Question 9?
Pyramidal neuron

Identify the tissue type:
White matter

Which of the following best describes this tissue?
Rich in myelinated axons
Match each sensory receptor with its function:
Photoreceptors
Detect light
Match each sensory receptor with its function:
Hair cells
Detect sound and equilibrium
Match each sensory receptor with its function:
Olfactory receptor neurons
Detect airborne chemicals (smell)
Match each sensory receptor with its function:
Gustatory receptor cells
Detect dissolved chemicals (taste)

Identify the labeled structure in the eye:
Retina
Word Bank: anterior chamber, posterior chamber, vitreous chamber
The space between the cornea and the iris is the ______.
Anterior chamber

Identify the component found in this retinal layer:
Cell bodies
In the ganglion cell layer of the retina, which component is primarily present?
Cell bodies
True/False
The outer plexiform layer of the retina primarily contains synapses between photoreceptors and bipolar cells.
True

Identify the structure:
Organ of Corti
Organ of Corti is located in which chamber?
Scala media

Identify the epithelium shown:
Pseudostratified columnar (olfactory epithelium)
Describe how olfactory receptor neurons are related to the olfactory nerve.
Olfactory receptor neurons are bipolar neurons whose axons bundle together to form the olfactory nerve (CN I) and pass through the cribriform plate to the olfactory bulb.

Identify the papilla type:
Circumvallate
Where is the Circumvallate papilla located?
Posterior tongue (in a V-shaped row)
Place the layers of the epidermis in correct order (superficial → deep):
Word Bank: stratum basale, stratum corneum, stratum spinosum, stratum granulosum, stratum lucidum
Stratum corneum → stratum lucidum → stratum granulosum → stratum spinosum → stratum basale

Identify the tissue types shown in the skin:
Stratified squamous epithelium + dense irregular CT

Identify the labeled structure:
Hair follicle

Identify the labeled structure:
Sebaceous gland

Identify the labeled structure:
Arrector pili muscle

Identify the gland type:
Eccrine gland

Identify the gland type:
Apocrine gland
Match each skin cell with its function:
Keratinocyte
Produces keratin
Match each skin cell with its function:
Melanocyte
Produces pigment (melanin)
Match each skin cell with its function:
Langerhans cell
Immune defense
Match each skin cell with its function:
Merkel cell
Touch receptor

Identify the tactile receptor:
Meissner corpuscle

Identify the tactile receptor:
Pacinian corpuscle

Distinguish the muscle tissue:
Skeletal muscle

Distinguish the muscle tissue:
Cardiac muscle

Distinguish the muscle tissue:
Smooth muscle

Identify the junction:
Neuromuscular junction
What tissue is on the presynaptic side?
Neuron
What tissue is on the postsynaptic side?
Skeletal muscle

Identify the junction:
Myotendinous junction
What tissue is on one side Myotendinous junction?
Skeletal muscle
What tissue is on the other side Myotendinous junction?
Dense regular connective tissue (tendon)

Identify the structure:
Sarcomere
Which protein forms the thick filaments?
Myosin
Which protein forms the thin filaments?
Actin

Distinguish the bone type:
Compact bone

Identify the cell:
Osteocyte

Identify the cell:
Osteoclast
Match the bone cell with its function:
Osteoblast
Builds bone
Match the bone cell with its function:
Osteoclast
Breaks down bone
Match the bone cell with its function:
Osteocyte
Maintains bone matrix
Which cartilage type is found in the trachea and provides flexible support?
Hyaline cartilage

Identify the labeled component:
Plasma

Compared to a normal smear, this sample shows abnormally shaped RBCs:
Sickle cell anemia
Identify the leukocyte:
Neutrophil
What is the primary function of Neutrophil?
Phagocytosis of bacteria

Identify the leukocyte:
Eosinophil
What is the primary function of Eosinophil?
Fight parasites
Identify the leukocyte:
Basophil
What is the primary function of Basophil?
Histamine release
Identify the leukocyte:
Monocyte
What is the function of a Monocyte?
Becomes macrophages

Identify the leukocyte:
Lymphocyte
What is the primary function of Lymphocytes?
Adaptive immunity
This smear shows abnormally elevated lymphocytes:
Leukemia

Compared to normal, this smear shows decreased WBC count:
Leukopenia